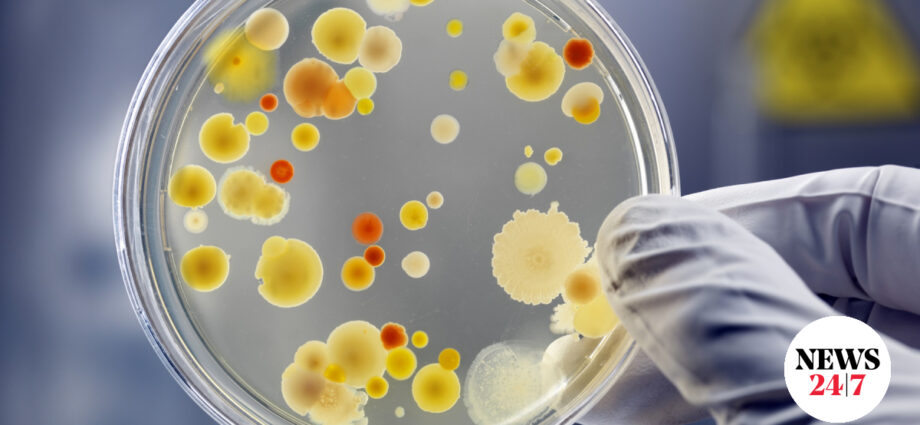

(Πηγή: www.news247.gr)
Ενημέρωση των υγειονομικών μονάδων όλης της χώρας σχετικά με το φαινόμενο και τις διαδικασίες που πρέπει να ακολουθούνται ως προς τη δήλωση των κρουσμάτων στον ΕΟΔΥ και την αποστολή των κλινικών καλλιεργημάτων στο Εθνικό Κέντρο Αναφοράς Σαλμονελλών, Σιγκελλών, δονακίων χολέρας, Λιστέριας και λοιπών εντεροπαθογόνων (ΕΚΑΣΣ) για περαιτέρω τυποποίηση.
Υψηλή θνησιμότητα καταγράφηκε, σύμφωνα με τον ΕΟΔΥ, στα κρούσματα λιστερίωσης στη χώρα μας το 2023, η οποία μεταδίδεται από μολυσμένα τρόφιμα.
Το 2023 καταγράφηκαν 31 κρούσματα λιστερίωσης στην Ελλάδα και τα 11 κατέληξαν, σύμφωνα με τον ΕΟΔΥ. Σε ποιες περιοχές της χώρας καταγράφηκαν, σε ποια τρόφιμα ανιχνεύεται.
Ενημέρωση του Ενιαίου Φορέα Ελέγχου Τροφίμων (ΕΦΕΤ) και… Πηγή